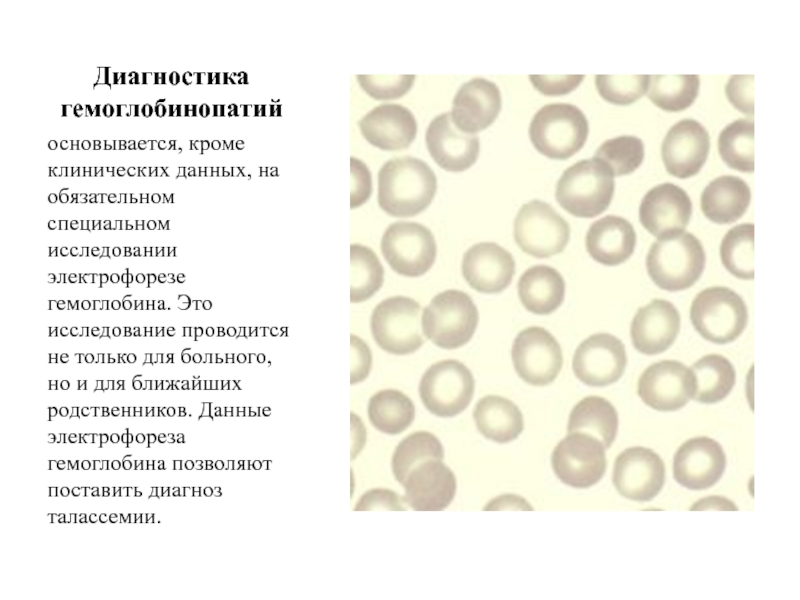

Слайд 2Анемии.
Группа разнообразных патологических состояний, в основе которых лежит уменьшение
содержания гемоглобина и (или) эритроцитов в крови. Анемии могут
быть приобретенными
и врожденными. В зависимости от причин, вызвавших заболевание, делятся на:
-- постгеморрагические, вызванные кровопотерями;
-- гемолитические из-за повышенного разрушения эритроцитов;
-- анемии вследствие нарушения образования эритроцитов.
Слайд 3Классификация
Существуют и другие классификации :
-- по размерам эритроцитов (при
уменьшении размера -- микроцитарные, при сохранении нормального размера -- нормоцитарные,
при увеличении размера -- макроцитарные),
-- по степени насыщенности эритроцитов гемоглобином (пониженная насыщенность -- гипохромные, нормальная --нормохромные, повышенная -- гиперхромные).
--по течению анемии могут быть острыми (развиваются быстро, протекают с выраженными клиническими признаками) и хроническими (развиваются постепенно, признаки вначале могут быть выражены минимально).
Слайд 4Анемии, обусловленны дефицитом различных веществ (железодефицитные, фолиеводефицитные, белководефицитные) возникают вследствие
недостаточного поступления в организм веществ, необходимых для образования гемоглобина. Они
нередки на первом году жизни, отмечаются при заболеваниях, сопровождающихся нарушением всасывания в кишечнике, при частых инфекциях и у недоношенных.
Наиболее распространены в этой группе алиментарные анемии (т.е. вызванные неполноценным или однообразным питанием).
Эти частые заболевания крови обсловлены анатомо-физиологическими особенностями детского организма (незрелость органов кроветворения, высокая их чувствительность к воздействиям неблагоприятных факторов окружающей среды).
Слайд 5Железодефецитная анемия.
- это клинико-гематологический синдром, характеризующийся нарушением синтеза гемоглобина в
результате дефицита железа, развивающегося на фоне различных патологических (физиологических) процессов,
и проявляющийся признаками анемии и сидеропении.
Слайд 6Бывают при недостатке в организме элемента железа. Проявления зависят от
степени тяжести заболевания. При легкой – снижается аппетит, ребенок вялый,
кожа бледная, иногда наблюдается небольшое увеличение печени и селезенки, в крови -- уменьшение содержания гемоглобина до 80 граммов на 1 литр, числа эритроцитов до 3,5 млн (в норме содержание гемоглобина от 170 г/л у новорожденных до 146 г/л у 14-15 летних, эритроцитов – соответственно от 5,3 млн до 5,0 млн). При заболевании средней тяжести заметно падает аппетит и активность ребенка, он вялый, плаксивый, кожа бледная и сухая, появляется шум в сердце, учащается ритм его сокращений, увеличиваются печень и селезенка, волосы становятся тонкими и ломкими. Содержание гемоглобина в крови снижается до 66 г/л, эритроцитов -- до 2,8 млн. При заболевании тяжелой степени ребенок отстает в физическом развитии, аппетит отсутствует, двигательная подвижность значительно снижена, частые запоры, выраженные сухость и бледность кожи, истонченные ногти и волосы легко ломаются. На лице и ногах отеки, печень и селезенка сильно увеличены, пульс резко учащен, имеются шумы в сердце, сосочки языка сглажены ("лакированный" язык). Количество гемоглобина снижается до 35 г/л, эритроцитов -- до 1,4 млн. Железодефицитные анемии нередко развиваются у недоношенных детей на 5-6 мес. жизни, когда запасы железа, полученные от матери, истощаются.

Слайд 7Витаминодефицитные анемии
обусловлены недостаточностью содержания витамина B12 и фолиевой кислоты,
как врожденной, так и приобретенной после заболеваний
желудочно-кишечного тракта.
Клиническая картина:
одышка, общая слабость, сердцебиение, жгучие боли в языке, поносы, нарушения походки, осязания (парестезии), при которых чувствительность снижена или повышена. Появляются сердечные шумы, сглаженность и покраснение сосочков языка, искажаются некоторые рефлексы. Возможно повышение температуры, иногда возникают психические расстройства. Печень и селезенка могут быть увеличены. Заболевание носит хронический характер и протекает с обострениями.
Слайд 8Белково-дефицитные анемии
- дефицит белка развивается при голодании или
одностороннем углеводистом
вскармливании детей, что приводит к нарушению синтеза глобина и белковых
транспортных соединений, снижению продукции эритропоэтина и эритропоэза, а также недостаточной выработке гормонов и ферментов (тканевых и желудочно-кишечного тракта).
Белково-дефицитная анемия характеризуется выраженными общедистрофическими изменениями, признаками полигиповитаминоза и нарушениями пигментного обмена. Характерны блефарит, дисхромия кожи и волос, повышенная их ломкость, пастозность тканей. Часто отмечаются анорексия, рвоты, поносы, уплотнение и увеличение печени. Анализы крови свидетельствуют, как правило, о тяжелой степени анемии, норморегенераторной, нормохромной, преимущественно нормоцитарной, но с выраженным анизо- и пойкилоцитозом. Продолжительность жизни эритроцитов сокращена в 2 раза (без признаков гемолиза). Снижен уровень белка в сыворотке, выражена диспротеинемия. Типичным примером преимущественно белководефицитной анемии является анемия при квашиоркоре.
Слайд 9Диагноз дефицитных анемий
ставят на основании анамнеза, клинической картины и лабораторных
данных: содержание гемоглобина ниже 100 г/л, сывороточного железа— ниже 14,3
мкмоль/л (80 мкг%). При белково-дефицитной анемии снижение содержания сывороточного белка ниже 60 г/л (6 г %), гипопохромия, появляются микроциты и макроциты, ретикулоциты до 1,7—2% и более, исчезают сидероциты. Для витамино-дефицитных анемий характерны гипохромия, мароцитоз и анизоцитоз эритроцитов.
Слайд 10Лечение дефицитных анемий
заключается в устранении причин заболевания, нормализации питания и
режима, назначении соответствующих препаратов: например при железодефицитной анемии —железа. До
уточнения диагноза и причин анемии не следует назначать витамины В12 или фолиевую кислоту.
Слайд 11Приобретенные гипопластические анемии
- возникают при угнетении кроветворной функции костного мозга.
Причины их - влияния на кроветворение ряда лекарственных веществ, ионизирующего
излучения, нарушения иммунной системы, функции эндокринных желез, длительного инфекционного процесса.
Характерными признаками являются бледность кожи, кровоточивость, носовые, маточные и другие кровотечения.
Часто наблюдаются инфекционные осложнения - пневмония, воспаление среднего уха (отит), почечной лоханки (пиелит), воспалительные изменения слизистой оболочки рта, прямой кишки.
Селезенка и лимфоузлы не увеличены.
Иногда наблюдается небольшое увеличение печени.
Слайд 12Лечение приобретенных гипопластических анемий.
Переливание эритроцитной массы, гормональная терапия (гидрокортизон или
преднизолон, ретаболил, введение антилимфоцитарного глобулина). Удаление селезенки или эмболизация (блокирование
кровеносных сосудов части или целой селезенки с оставлением на месте этого органа), иногда пересадка костного мозга.
При кровотечениях -- кровоостанавливающие средства 1 (тромбоцитная масса, аминокапроновая кислота и др.).
Профилактика -- контроль за состоянием крови при длительном лечении веществами, вызывающими угнетение кроветворения.
Слайд 13Врожденные формы анемии.
Анемия Фанкони: первым проявлением повреждения почечных канальцев служит
синдром Фанкони - почечный проксимальноканальцевый ацидоз ,сопровождающийся потерей глюкозы, аминокислот
и нарушением способности почек подкислять и концентрировать мочу.
Анемия Фанкони наследуется аутосомно-рецессивно и проявляется прогрессирующей панцитопенией , пороками развития ,предрасположенностью к злокачественным новообразованиям ,а также ломкостью хромосом и повышенной чувствительностью к химическим мутагенам . Характерные признаки - низкорослость ,гиперпигментация (светло-коричневые пятна на коже) ,пороки развития почек ,пороки развития мочевых путей ,микрофтальмия ,умственная отсталость и аномалии скелета ,в основном аномалии лучевой кости и аномалии большого пальца кисти .
Клетки больных чрезвычайно чувствительны к мутагенам, в том числе к диэпоксибутану ( бутандиендиэпоксиду ) и циклофосфамиду .
Комплементационный анализ выявил по крайней мере пять различных генов, мутации которых вызывают анемию Фанкони. Один из генетических вариантов заболевания - тип С - обусловлен мутацией гена FANCC , участвующего в ответе клетки на повреждение ДНК.
Заболеваемость острыми миелоидными лейкозами возрастает при наследственных болезнях, сопровождающихся повышенной ломкостью хромосом , - анемии Фанкони, атаксии-телеангиэктазии , синдроме Костмана и синдроме Блума .

Слайд 14Врожденная парциальная гипопластическая анемия Джозефса —Даймонда — Блекфена
- выявляется
обычно на первом году жизни. Заболевание нередко протекает доброкачественно. Клиническая
картина развивается постепенно: появляются вялость, бледность кожи и слизистых оболочек, снижается аппетит. В крови снижается содержание гемоглобина, число эритроцитов и ретикулоцитов при нормальном количестве лейкоцитов и тромбоцитов.
Слайд 15Анемия Эстрена — Дамешека
(S. Estren, р. 1918 г., американский педиатр;
W. Dameshek, р. 1900 г., американский педиатр) — наследственная гипопластическая
анемия у детей с неэффективностью всех трех ростков кроветворения в костном мозге; отличается от анемии Фанкони отсутствием других аномалий развития.
Слайд 16Лечение.
- переливание эритроцитной массы, удаление селезенки или эмболизация, кровоостанавливающие средства
при кровоточивости.
Слайд 17Гемолитические анемии
развиваются из-за усиленного распада эритроцитов, вследствие гемолитической болезни
новорожденных , в конечной стадии почечной недостаточности с повышением содержания
мочевины в крови (уремии), при дефиците витамина Е. Могут быть и наследственными (дефект строения эритроцитов и гемоглобина).
Лечение: то же.
Слайд 18Причины возникновения гемолитических анемий.
- у детей могут быть несовместимость крови
матери и плода, что наблюдается при гемолитической болезни новорожденных, аутоаллергии,
уремии, недостаточности витамина Е. Наследственные гемолитические анемии обусловлены наследственным дефектом эритроцитов, наличием аномальных гемоглобинов в эритроцитах или угнетением синтеза нормальных гемоглобинов, а также аномалией ферментов. К наследственным гемолитическим анемиям относятся гемоглобинопатии.
Слайд 19Гемоглобинопатия
- наследственное или врождённое изменение или нарушение структуры белка
гемоглобина, обычно приводящее к клинически или лабораторно наблюдаемым изменениям в
его кислород-транспортирующей функции либо в строении и функции эритроцитов.
К наиболее часто встречающимся и известным гемоглобинопатиям относятся серповидно-клеточная анемия, наследственный микросфероцитоз, персистенция фетального гемоглобина.
Гемоглобинопатии классифицируются на качественные и количественные.
Слайд 20Серповидно-клеточная анемия
- это наследственная гемоглобинопатия, связанная с таким нарушением
строения белка гемоглобина, при котором он приобретает особое кристаллическое строение
- так называемый гемоглобин S. Эритроциты, несущие гемоглобин S вместо нормального гемоглобина А, под микроскопом имеют характерную серпообразную форму (форму серпа), за что эта форма гемоглобинопатии и получила название серповидно-клеточной анемии.
Серповидно-клеточная анемия весьма распространена в регионах мира, эндемичных по малярии, причем больные серповидно-клеточной анемией обладают повышенной (хотя и не абсолютной) врожденной устойчивостью к заражению различными штаммами малярийного плазмодия. Серповидные эритроциты этих больных также не поддаются заражению малярийным плазмодием в пробирке.
Слайд 21Наследственный микросфероцитоз, также известный как болезнь Минковского - Шоффара
-
наследственно детерминируемое заболевание, передающееся по аутосомно-доминантному типу, характеризуется дефектом белков
мембраны эритроцитов. Как следствие, при данном процессе отмечается нарушение ее проницаемости, поступает избыточное количество ионов натрия.
Заболевание описано более 100 лет назад. В конце XIX в. установлено наследование болезни (1885; Wilson, 1890; Minkowsky, 1900; Chauffard, 1907).
Болезнь широко распространена в различных странах Европы (частота 1 : 5000). Значительно реже болезнь встречается в Японии, странах Африки.
Слайд 22Персистенция фетального гемоглобина
— наследственная гемоглобинопатия, при которой после рождения
ребёнка не происходит постепенной замены фетального гемоглобина, так называемого гемоглобина
F на «взрослый» тип гемоглобина — гемоглобин А, обладающий большей функциональной стабильностью в широком интервале pH, хотя и меньшей кислород-связывающей способностью. При этом, поскольку фетальный гемоглобин менее стоек и стабилен, у страдающих этой формой гемоглобинопатии укорочен срок жизни эритроцитов, повышен гемолиз и повышено разрушение эритроцитов в селезёнке, со всеми вытекающими последствиями в виде перегрузки организма железом и желчными пигментами и хронического «перенапряжения» эритроцитарного ростка костного мозга.
Слайд 23Классификация.
Качественные обусловлены заменой аминокислот в полипептидных цепях. Замена аминокислоты валина
на глутамат в 6-м положении цепи приводит к образованию аномального
гемоглобина S, что лежит в основе развития серповидно-клеточной анемии.
Количественные гемоглобинопатии связаны со скоростью синтеза или полипептидных цепей глобина. Угнетение скорости синтеза цепи приводит к развитию талассемии, угнетение синтеза цепи лежит в основе заболевания талассемии.
Слайд 24Диагностика гемоглобинопатий
основывается, кроме клинических данных, на обязательном специальном исследовании
электрофорезе гемоглобина. Это исследование проводится не только для больного, но
и для ближайших родственников. Данные электрофореза гемоглобина позволяют поставить диагноз талассемии.
Слайд 25Лечение.
Основу ведения больных с гемоглобинопатиями составляет профилактика осложнений и их
лечение. Следует избегать обезвоживания и пребывания на большой высоте, а
также незамедлительно лечить все инфекции. Назначают фолиевую кислоту , 1 мг/сут. В раннем возрасте (до поражения селезенки) показано введение пневмококковой и менингококковой вакцин, а также вакцины против Haemophilus influenzae типа В . Детям в возрасте до 6 лет назначают профилактическую антибиотикотерапию.
При трофических язвах голеней показаны длительный постельный режим, а также трансплантация кожи. При приапизме назначают обезболивающие средства и нифедипин . Длящийся более суток приапизм требует хирургического лечения. Импотенция - частое осложнение приапизма.
Чаще всего врач сталкивается с болевыми кризами , лечение которых представляет собой трудную задачу. Больного согревают, проводят ингаляции кислорода и инфузионную терапию (последняя необходима потому, что из-за некрозов почечных сосочков снижается концентрационная способность почек). Для уменьшения частоты кризов (особенно при тяжелом течении болезни) используют также повторные переливания эритроцитарной массы, но это может привести к гемосидерозу .
При остром синдроме грудной клетки кроме инфузионной терапии и ингаляций кислорода назначают антибиотики широкого спектра, например цефтриаксон , а также эритромицин (для профилактики микоплазменной инфекции ).
При развитии дыхательной недостаточности ( РаО2 ниже 60 мм рт. ст.) может потребоваться обменное переливание крови.
У беременных с серповидноклеточной анемией высок риск гибели плода
Специфическое лечение. Гидроксимочевина - единственный препарат, препятствующий образованию серповидных эритроцитов, что подтверждено контролируемыми испытаниями. Действуя на эритропоэз, этот препарат стимулирует синтез гамма-цепей глобина. Повышенная концентрация гемоглобина F препятствует изменению формы эритроцитов и уменьшает частоту кризов . Действие гидроксимочевины усиливается при одновременном назначении препаратов эритропоэтина . Обычно это лечение назначают лишь при тяжелом течении болезни.
Излечения удается достичь лишь с помощью аллотрансплантации костного мозга. Поскольку ранняя и среднесрочная летальность после трансплантации составляет 5-10%, отбор больных для этого лечения весьма труден.

Слайд 26Тяжелое осложнение - анемическая кома.
Симптомы и течение. Перед потерей
сознания ребенка знобит, иногда повышается температура тела, дыхание становится поверхностным
и учащенным, так как легкие плохо расправляются и в кровь поступает недостаточное количество кислорода. В этот момент частота пульса возрастает, артериальное давление снижается, содержание гемоглобина в крови резко падает. Кожа бледнеет, приобретая желтушный оттенок. Возможно развитие судорог, менингеальных симптомов: головная боль, рвота, повышение чувствительности, невозможность согнуть голову вперед (ригидность затылочных мышц). Возникают различные патологические рефлексы -- при пассивном сгибании вперед головы больного, лежащего на спине, происходит сгибание ног в тазобедренных и коленных суставах; при сгибании в тазобедренном суставе одной ноги и разгибании ее в коленном суставе непроизвольно сгибается и другая нога.
В крови уменьшается количество нормальных эритроцитов (эритроциты недостаточно насыщены кислородом, имеют большие размеры).